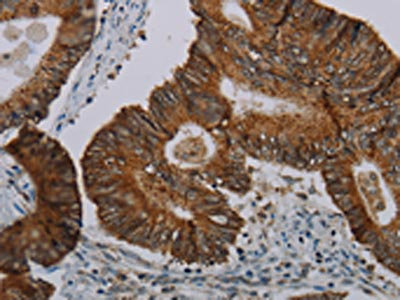

-
中文名稱:CFLAR兔多克隆抗體
-
貨號:CSB-PA877207
-
規格:¥1100
-
圖片:
-
The image on the left is immunohistochemistry of paraffin-embedded Human ovarian cancer tissue using CSB-PA877207(CFLAR Antibody) at dilution 1/20, on the right is treated with synthetic peptide. (Original magnification: ×200)
-
The image on the left is immunohistochemistry of paraffin-embedded Human colon cancer tissue using CSB-PA877207(CFLAR Antibody) at dilution 1/20, on the right is treated with synthetic peptide. (Original magnification: ×200)
-
Gel: 8%SDS-PAGE, Lysate: 40 μg, Lane: Mouse heart tissue, Primary antibody: CSB-PA877207(CFLAR Antibody) at dilution 1/200, Secondary antibody: Goat anti rabbit IgG at 1/8000 dilution, Exposure time: 4 minutes
-
-
其他:
產品詳情
-
Uniprot No.:
-
基因名:
-
別名:c FLIP antibody; c FLIPL antibody; c FLIPR antibody; c FLIPS antibody; c-FLIP antibody; c-FLIPL antibody; c-FLIPR antibody; c-FLIPS antibody; CASH antibody; CASP8 and FADD like apoptosis regulator antibody; CASP8 and FADD-like apoptosis regulator subunit p12 antibody; CASP8AP1 antibody; Caspase homolog antibody; Caspase like apoptosis regulatory protein antibody; Caspase related inducer of apoptosis antibody; Caspase-eight-related protein antibody; Caspase-like apoptosis regulatory protein antibody; Casper antibody; cellular flice inhibitory protein antibody; Cellular FLICE-like inhibitory protein antibody; CFLA antibody; Cflar antibody; CFLAR_HUMAN antibody; CLARP antibody; FADD like anti apoptotic molecule antibody; FADD-like antiapoptotic molecule 1 antibody; FLAME antibody; FLAME-1 antibody; FLAME1 antibody; FLIP antibody; I FLICE antibody; I-FLICE antibody; Inhibitor of FLICE antibody; MACH-related inducer of toxicity antibody; MRIT antibody; OTTHUMP00000163715 antibody; OTTHUMP00000206475 antibody; OTTHUMP00000206476 antibody; OTTHUMP00000206478 antibody; OTTHUMP00000206479 antibody; OTTHUMP00000206480 antibody; OTTHUMP00000206482 antibody; OTTHUMP00000207360 antibody; Usurpin antibody; Usurpin beta antibody
-
宿主:Rabbit
-
反應種屬:Human,Mouse
-
免疫原:Synthetic peptide of Human CFLAR
-
免疫原種屬:Homo sapiens (Human)
-
標記方式:Non-conjugated
-
抗體亞型:IgG
-
純化方式:Antigen affinity purification
-
濃度:It differs from different batches. Please contact us to confirm it.
-
保存緩沖液:-20°C, pH7.4 PBS, 0.05% NaN3, 40% Glycerol
-
產品提供形式:Liquid
-
應用范圍:ELISA,WB,IHC
-
推薦稀釋比:
Application Recommended Dilution ELISA 1:1000-1:2000 WB 1:200-1:1000 IHC 1:25-1:100 -
Protocols:
-
儲存條件:Upon receipt, store at -20°C or -80°C. Avoid repeated freeze.
-
貨期:Basically, we can dispatch the products out in 1-3 working days after receiving your orders. Delivery time maybe differs from different purchasing way or location, please kindly consult your local distributors for specific delivery time.
-
用途:For Research Use Only. Not for use in diagnostic or therapeutic procedures.
相關產品
靶點詳情
-
功能:Apoptosis regulator protein which may function as a crucial link between cell survival and cell death pathways in mammalian cells. Acts as an inhibitor of TNFRSF6 mediated apoptosis. A proteolytic fragment (p43) is likely retained in the death-inducing signaling complex (DISC) thereby blocking further recruitment and processing of caspase-8 at the complex. Full length and shorter isoforms have been shown either to induce apoptosis or to reduce TNFRSF-triggered apoptosis. Lacks enzymatic (caspase) activity.
-
基因功能參考文獻:
- cFLIP appears to bind to IKKalpha to prevent IKKalpha from phosphorylating and activating IRF7. PMID: 29222334
- High c-FLIP expression is associated with resistance to sorafenib via reducing ER stressrelated autophagy in hepatocellular carcinoma. PMID: 30066934
- The knockdown of endogenous c-FLIP revealed that this protein regulates hepatitis B virus replication through two different mechanisms. (i) c-FLIP interacts with HBx and protects it from ubiquitin-dependent degradation. (ii) c-FLIP regulates the expression or stability of hepatocyte nuclear factors (HNFs), which have critical roles in HBV transcription and maintenance of hepatocytes. PMID: 29875248
- Nogo-B was shown to play an important negative role in apoptotic signaling through its interaction with c-FLIP in colorectal cancer cells. PMID: 29684585
- Compared to normal tissues, hepatocellular carcinoma tissues had lower miR-20 and higher CFLAR expression. PMID: 28537677
- Investigations of underlying molecular mechanisms of TNFR1 signaling showed that PDF affects TNFR1 signaling at the proapoptotic signaling pathway by upregulation of IkappaBalpha and downregulation of cFLIPL. PMID: 28096440
- c-FLIP expression was significantly decreased in organs of septic rats compared with control rats, and that c-FLIP overexpression protected HUVECs from LPS+CHX-induced apoptosis in vitro. PMID: 28498469
- case-control study, including 600 hepatocellular carcinoma (HCC) and 600 HBsAg positive controls without HCC, was conducted to assess the relationship between 11 tagging SNPs in CASP8, CASP10 and CFLAR and HBV-related HCC risk .These results suggest that the CASP8 -652 6N ins/del polymorphism may play a protective role in the development, progression, and survival of HBV-related HCC among the Chinese Han population. PMID: 28643196
- Cordycepin induces apoptosis through autophagy-mediated downregulation of c-FLIPL in human non-small cell lung carcinoma cells. PMID: 28035061
- High c-FLIP expression is associated with lung cancer. PMID: 26992204
- miRNA-708 acts as a tumor suppressor because it negatively regulates the anti-apoptotic protein c-FLIPL and regulates the sensitivity of renal cancer cells to various apoptotic stimuli. PMID: 27092874
- The (fli:GFP) Casper zebrafish embryo can be used as an efficient animal model to study metastatic behavior of human CM cells and warrants further testing of drug efficacy to aid care of CM patients. PMID: 29204645
- Inhibition of BET bromodomain-dependent XIAP and FLIP expression sensitizes KRAS-mutated non-small cell lung cancer to pro-apoptotic agents. PMID: 27607580
- the c-FLIP and NOXA/Mcl-1 axis participated in the synergistic effect of pemetrexed plus cisplatin in human choroidal melanoma cells PMID: 28863158
- The strongest interaction result in relation to overall breast cancer risk was found between CFLAR-rs7558475 and current smoking (ORint = 0.77, 95% CI: 0.67-0.88, pint = 1.8 x 10(-4) ). The interaction with the strongest statistical evidence was found between 5q14-rs7707921 and alcohol consumption (ORint =1.36, 95% CI: 1.16-1.59, pint = 1.9 x 10(-5) ) in relation to ER- disease risk PMID: 28670784
- Data in this study show that cFLIPL inhibits IFN regulatory factor 3 (IRF3), a transcription factor central for IFN-beta and IFN-stimulated gene expression. PMID: 27342840
- CFLAR levels were substantially decreased in the livers of subjects with NAFLD and NASH, as compared to that in nonsteatotic controls. PMID: 28218919
- CFLAR role in the necroptosis in fibroblasts PMID: 27721066
- Our results postulate that thymoquinone induces apoptosis through downregulating c-FLIP and Bcl-2 which can be utilized as a chemotherapeutic agent to treat renal carcinoma. PMID: 27573448
- Data show that heterogeneous nuclear ribonucleoprotein K (hnRNPK) stabilized of cellular FLICE-inhibitory protein (c-FLIP) protein through inhibition of glycogen synthase kinase 3 beta (GSK3beta) Ser9 phosphorylation during the TNF-related aoptosis-inducing ligand (TRAIL)-induced apoptosis. PMID: 26972480
- cFLIP long form shRNA serves a specific inhibitory role in cellular proliferation through inducing the activation of the JNK pathway in A875 cells. PMID: 26847085
- Study demonstrated the function of FLIPL in facilitating hepatocellular carcinoma cells (HCC) aerobic glycolysis by modulating SGLT1-mediated glucose uptake and FLIPL expression level was positively correlated with SGLT1 expression level in patients with HCC. PMID: 27178057
- Data show that suppression of autophagy effectively attenuated cytotoxicity induced by Chal-24 and TRAIL combination, which was associated with attenuation of c-FLIP(L) protein and cellular inhibitor of apoptosis proteins (c-IAPs) degradation. PMID: 26448608
- neither c-FLIP nor procaspase-8 prodomain terminates the DED chain, but rather the dissociation/association rates of procaspase-8 define the stability of the chain and thereby its length. PMID: 26494467
- High FLIP expression is associated with Pancreatic cancer. PMID: 26716649
- A dual role for cFLIP in the maintenance of breast cancer stem cell viability, dependent upon its subcellular distribution. PMID: 26667821
- This conservation of IKK activation among the cFLIP family using different mechanisms suggests that the mechanism plays a critical role in their function. PMID: 26865630
- procaspase-8:c-FLIPL exhibits localized enzymatic activity and is preferentially an activator, promoting DED-mediated procaspase-8 oligomer assembly, whereas procaspase-8:c-FLIPS lacks activity and potently blocks procaspase-8 activation PMID: 26990987
- Reduced miR-512 and the elevated expression of its targets cFLIP and MCL1 localize to neurons with hyperphosphorylated Tau protein in Alzheimer disease. PMID: 26258756
- CDDO-Me rapidly reduced the protein levels of c-FLIPL and overexpression of c-FLIPL blocked CDDO-Me-induced cell death, but not vacuolation PMID: 26053096
- Identification and Characterization of the Interaction Site between cFLIPL and Calmodulin. PMID: 26529318
- Upregulation of hTERT+ in human lung epithelial cells and subsequent downregulation of FLIP by shFLIP-RNA annulled hTERT-mediated resistance to apoptosis. PMID: 25951185
- Activation of AKR1C1/ERbeta induces apoptosis by downregulation of c-FLIP in prostate cancer cells. PMID: 25816367
- The knockdown of c-FLIPL led to enhanced Th1 differentiation and elevated IL-4 production by Th2 cells, whereas the knockdown of c-FLIPS diminished GATA3 expression and IL-4 production. PMID: 25019384
- A complete inhibition of PS1-induced apoptosis was achieved by knockdown of PS1-associated protein (PSAP), a mitochondrial proapoptotic protein that forms a complex with Bax upon induction of apoptosis, in the presence of gamma-secretase inhibitor. PMID: 26025363
- Data show that decreased type I interferon gene expression in T cell subsets of human CASP8 and FADD-like apoptosis regulating protein c-FLIPS transgenic female mice. PMID: 24816846
- Increased c-FLIP expression is associated with cutaneous T-cell lymphoma. PMID: 25578476
- The four structure-based mutants (E80A, L84A, K169A and Y171A) of c-FLIP death effector domains disturb the interaction with FADD death effector domain, and that these mutations lower the stability of the c-FLIP death effector domain. PMID: 24355299
- Transfection of the c-FLIPp43 expression vector may induce the protein expression of NF-kappaBp65 and promote the activation of the NF-kappaB signaling pathway in the A375 melanoma cell line. PMID: 25017325
- Over-expression of FLIP-L is associated with breast cancer. PMID: 25230899
- cytoplasmic c-FLIPL/s was an independent prognostic parameters for progression-free survival in locally advanced rectal cancer PMID: 24711168
- c-FLIP negativity identifies 9% of patients with a highly aggressive disease course (P = 0.0001) and thus is a valuable prognostic biomarker in pancreatic cancer. PMID: 24005232
- cFLIP upregulated the expression of viral restriction factors. PMID: 23696271
- ERK controls epithelial cell death receptor signalling and c-FLIP in ulcerative colitis PMID: 23371318
- The knockout of c-FLIP and Hsp27 genes together enhances apoptosis even under 1 mu M, rather than low concentration, of doxazosin in PC-3 cells. PMID: 23853530
- An increased expression of c-FLIP may be an important factor in the progression of cervical cancer PMID: 23518915
- findings provide the first evidence showing that mTORC2 stabilizes FLIP(S), hence connecting mTORC2 signaling to the regulation of death receptor-mediated apoptosis PMID: 23319802
- novel ROS-dependent post-translational modifications of the c-FLIP protein that regulate its stability, thus impacting sensitivity of cancer cells to TRAIL. PMID: 23519470
- review of molecular mechanisms that control c-FLIP expression and current research into inhibitors of the protein [review] PMID: 21071136
- review of the structural and functional biology of c-FLIP with direct relevance to carcinogenesis [review] PMID: 22781394
顯示更多
收起更多
-
蛋白家族:Peptidase C14A family
-
組織特異性:Widely expressed. Higher expression in skeletal muscle, pancreas, heart, kidney, placenta, and peripheral blood leukocytes. Also detected in diverse cell lines. Isoform 8 is predominantly expressed in testis and skeletal muscle.
-
數據庫鏈接:
Most popular with customers
-
-
YWHAB Recombinant Monoclonal Antibody
Applications: ELISA, WB, IHC, IF, FC
Species Reactivity: Human, Mouse, Rat
-
Phospho-YAP1 (S127) Recombinant Monoclonal Antibody
Applications: ELISA, WB, IHC
Species Reactivity: Human
-
-
-
-
-